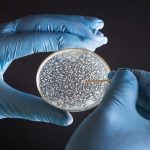
Bozza automatica 196

L’uomo, un 27enne del posto, è stato arrestato dagli agenti di polizia e accusato di furto aggravato.
Venerdì sera la polizia ha arrestato all’interno dell’ospedale Galliera di Genova un 27enne che tentava di rubare metadone. L’uomo, un genovese pregiudicato per reati contro il patrimonio, è stato sorpreso da un’infermiera mentre trafficava nelle vicinanze della cassaforte dove sono custoditi gli stupefacenti per uso terapeutico.
Colto sul fatto, si è dato alla fuga, buttando via i nove flaconi che era riuscito a trafugare. Una fuga di breve durata, però. A fermarlo hanno infatti provveduto una guardia giurata e altri infermieri, che lo hanno poi consegnato agli agenti intervenuti di lì a poco. Nei suoi confronti è scattata l’accusa di furto aggravato.
Redazione Nurse Times

Lascia un commento